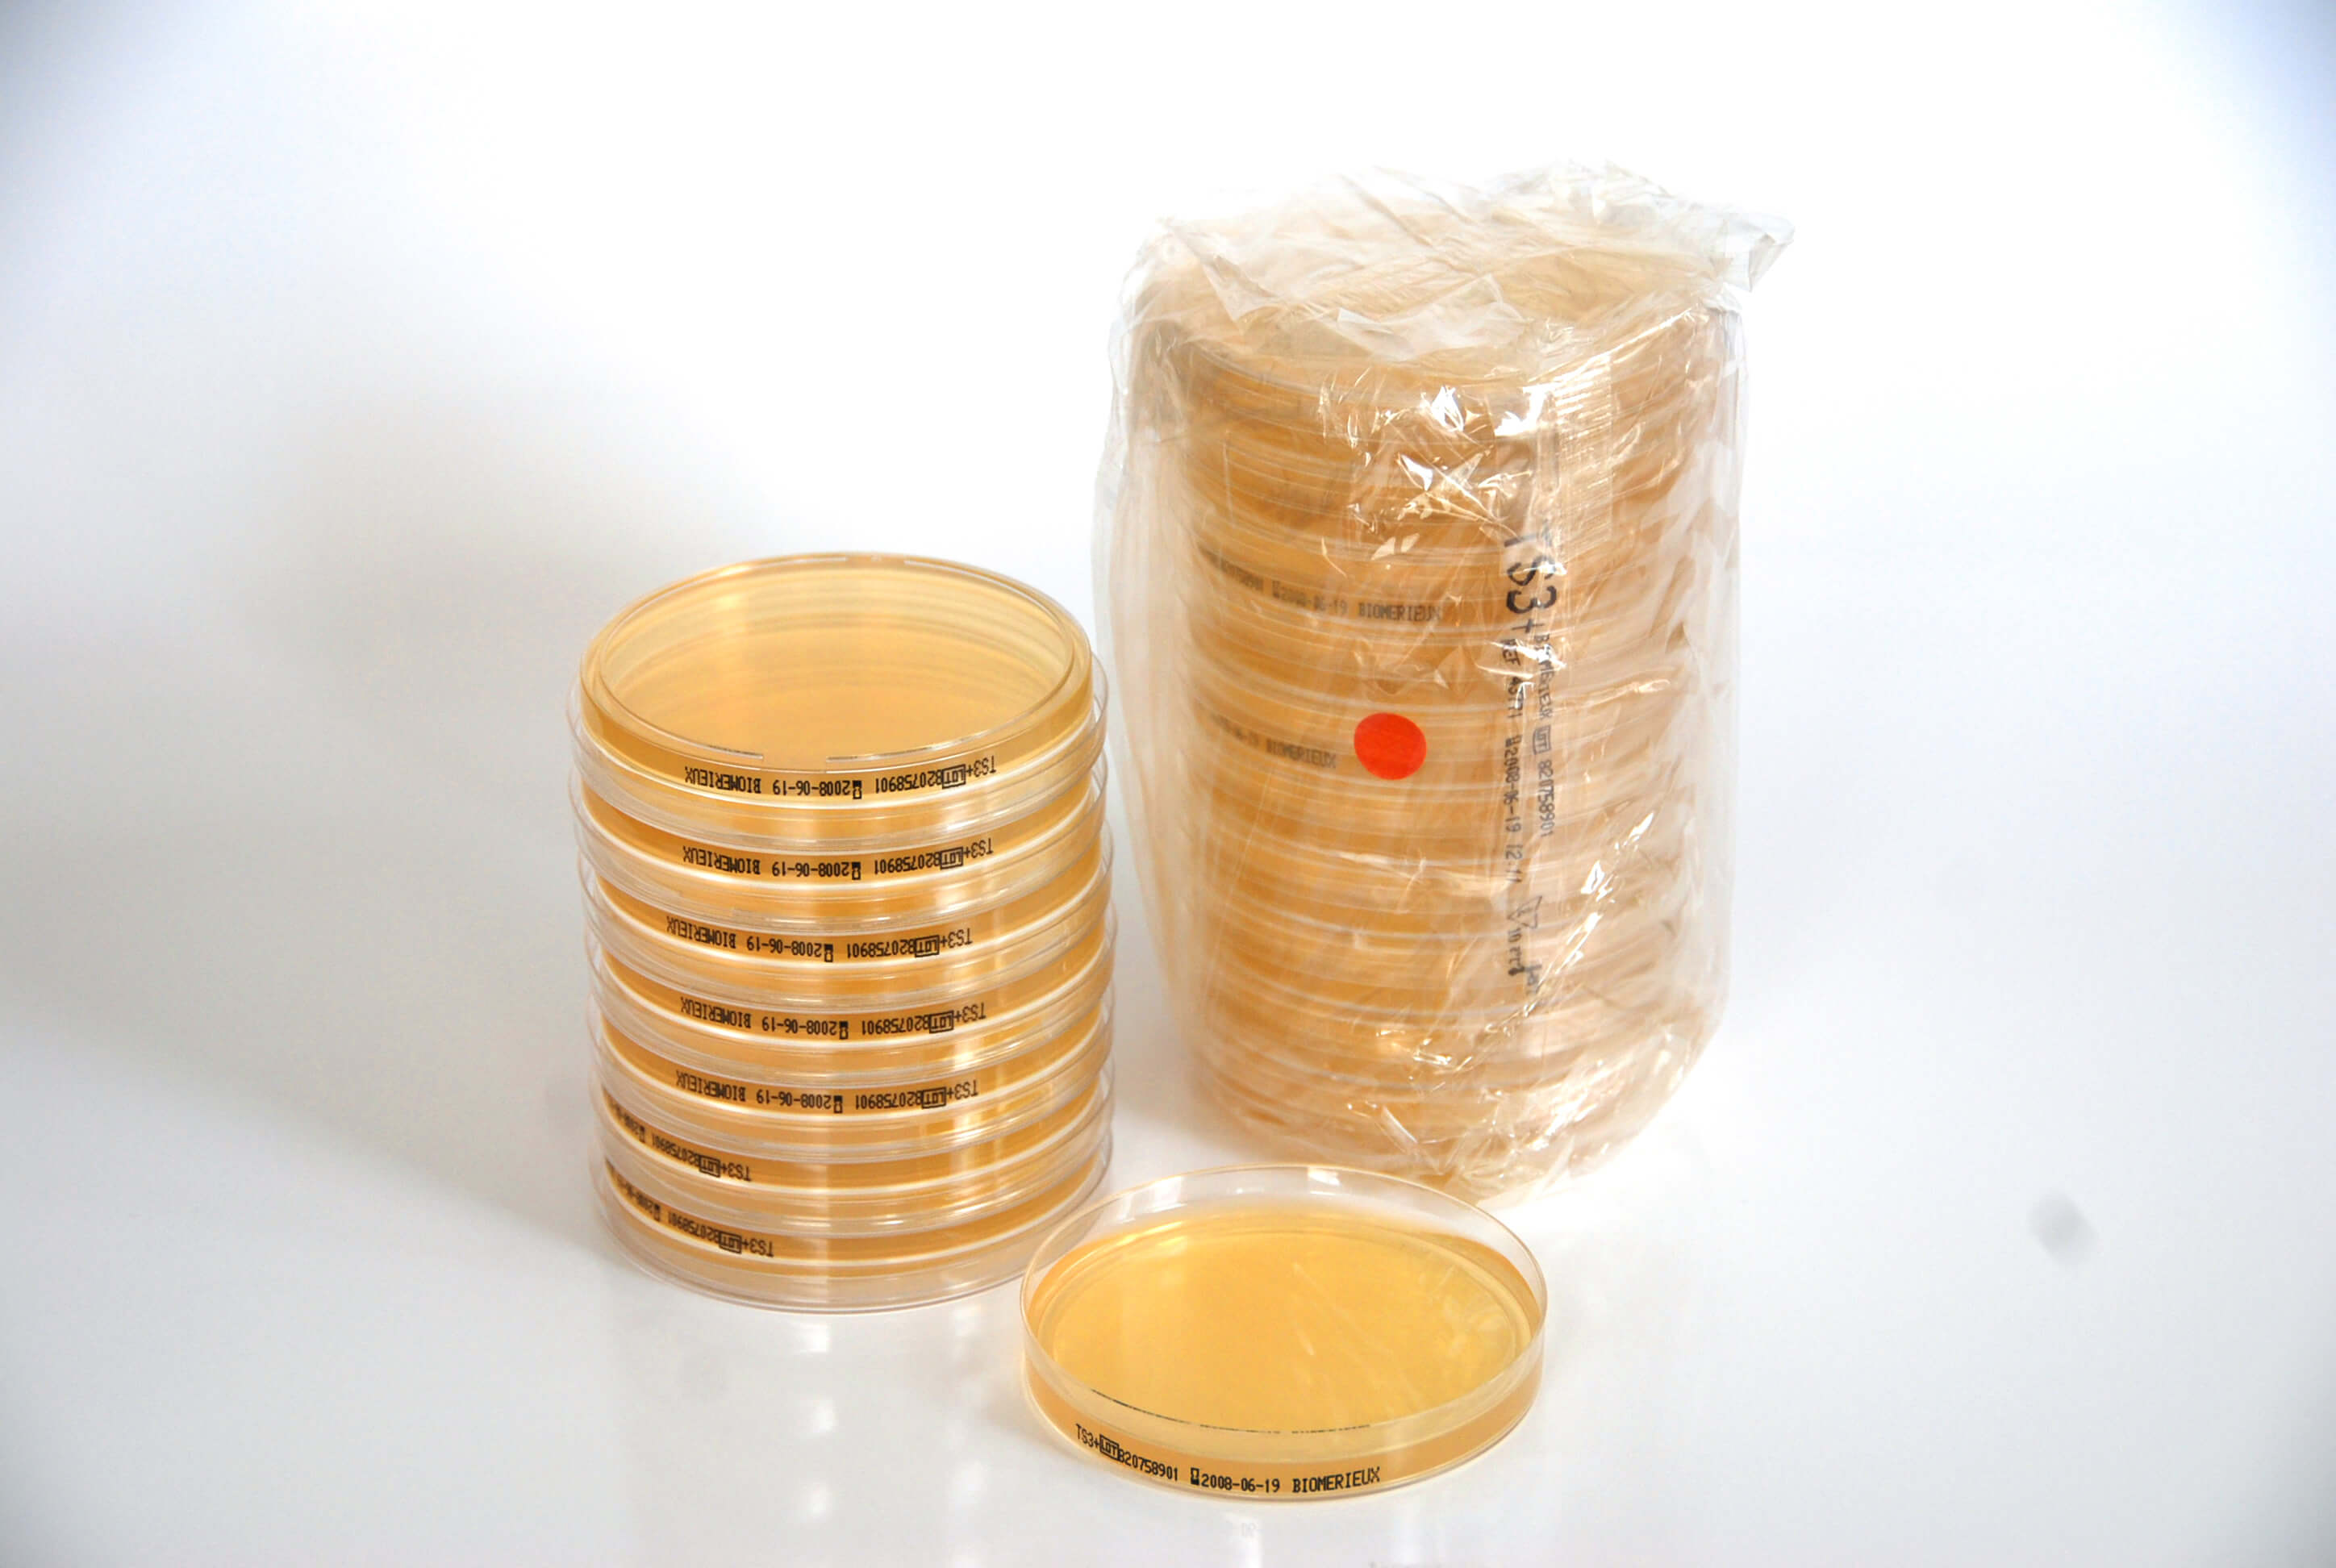
Biomerieux A3p Industrie Pharmaceutique Biotechnologie

AIR IDEAL® 3P is the first air sampler giving full transparency on its highlighted the superior performance of this new instrument compared to the main commerciallyavailable air samplers Features User friendly Validation of the use of the bioMérieux air IDEAL 3P Air sampler The air IDEAL 3P from bioMérieux is an impactor type ofAir IDEAL 3P is delivered with a hook for suspending it in a glove box during decontamination phases Even though sampling can be done while suspended, it is preferable to position Air IDEAL 3P along the axis of oneway flow at the air outlets Page 29 Screwing On The Sampling GridJan 14, 16 · Air IDEAL 3P is designed to run on a battery (6 NiMH batteries connected in series, each with a nominal voltage of 12 V) Air IDEAL 3P can also be powered and/or recharged using one of the adapters indicated or an equivalent one CAUTION!

Airideal 3p Brochure
Air ideal 3p calibration
Air ideal 3p calibration-Air IDEAL®3P™ Traceability Solution AeroBioCollector User's Manual Revisions1 7BRevisions The list of revisions below summarizes replacements or additional pages in your User's Manual Version Date of printing Modifications Pages modified A 01/01 Bilingual (FR / EN) All B 01/04 Multilingual (FR / EN / ES / IT / DE / PT) AllSize, air Ideal 3P collects from 85% to 139% of the particles versus the nonportable Gold Standard air sampler This study confirmed that air IDEAL 3Phas a high level of collection of the particles of interest (above 5 µm) For these significant particle sizes, air IDEAL 3P was shown to have




Biomerieux Microbiological Air Sampler Air Ideal 3p For Clean Room Airideal Eur 763 16 Picclick Fr
Solutions for Chapter 4 Problem 3P If 250(ft)3(s)–1 of air at 122 Here, is the pressure of the air, is the volumetric flow rate, is the ideal gas constant, is the initial temperature of air, is the heat capacity of air Chapter 4, Problem 3P is solved View this answer View this answer View this answer done loading24 Feb, 17 environmentsThis agreement provides bioMérieux with the perfect addition to its line of environmental controls, comprised notably of the air IDEAL 3P air sampler and a complete range of readytouse media The swab can be used with bioMérieux culture media plates to provide a quantitative determination of the bioburdenPerformance Air Suspension from Air Lift Performance is our premium line of struts/shocks with features like 30level damping adjustment, camber adjustment, threaded shock
Aug 18, 16 · FDA – 04 air IDEAL® 3P is a new standard in air sampling fully transparent on its collection efficiency following the ISO standard 444 Proven Efficiency air IDEAL® 3P Environmental Monitoring in Total Confidence air IDEAL® 3P has been third party validated to provide customers with a scientifically sound air sampling methodStarting at $699 Experience the intersection of onpoint pricing, quality and customization with 3S, the optimal entrylevel air management system forNote The ACDC power supply adapter must have the following characteristics Voltage 12 VDC Power
3P Both systems come with the Air Lift Performance 3 controller, a device that is truly amazing to hold and to use Take full control of your 3H/3P system with a FREE mobile app with no additional hardware needed, for all compatible devices By combining the ECU, pressure manifold, and Bluetooth module into one compact unit, the new manifoldAir sampler Theair IDEAL 3Pfrom bioMérieux is an impactor type of instrument based on the principle described by Andersenet al(ref 1), in which air is aspirated through a grid perforated with a pattern of 286 calibrated holes The resulting air streams containing microbial particles areAir Plants Snake Plants Fiddleleaf Figs Aloe Vera Plants Orchids ANNUALS VS PERENNIALS Annuals Annuals like petunias, marigolds and sunflowers go through their entire life cycle in one growing season and need to be replanted every year Their continuous bloom throughout the season creates a bright and showy choice for borders, beds and




Katkars Clinical Industrial Products




Used Biomerieux Air Ideal 3p Traceability Air Sampling Monitor W Power Supply Lab General Un Venta Del La Dotmed Listado
Air Force Research Laboratory (AFMC) AFRL/RQRP 10 E Saturn Blvd Edwards AFB CA 9 SPONSORING / MONITORING AGENCY NAME(S) AND ADDRESS(ES) 10 SPONSOR/MONITOR'S ACRONYM(S) Air Force Research Laboratory (AFMC) AFRL/RQR 5 Pollux Drive 11 SPONSOR/MONITOR'S REPORT Edwards AFB CA NUMBER(S) AFRLRQIdealAir 7369 Damper, 12inch Diameter, Made Gauge Galvanized Steel with HeavyDuty Springs Prevents Back Drafts, Silver 40 out of 5 stars 12 $7042 Usually ships within 6 to 10 days IdealAir ducting, 12 Inch, Silver 45 out of 5 stars 8 $5465 Only 3 left in stockOfficial website for Alaska Airlines the premier airline of the West Coast – Find the best flights deals, book flights, vacation packages, checkin, get flight status and more




Air Ideal 3p Powerful And Simple Air Testing Biomerieux Industrial Microbiology



Katkars Clinical Industrial Products
Air IDEAL ® 3 P is a new standard in air sampling fully transparent on its collection efficiency following the ISO standard 44 4 Proven Efficiency air IDEAL ® 3 P Environmental Monitoring in Total Confidence air IDEAL ® 3 P has been third party validated to provide customers with a scientifically sound air sampling method This validation focused onView and Download bioMerieux Air IDEAL 3P user manual online air IDEAL 3P laboratory equipment pdf manual downloadAIR IDEAL® 3P® Traceability Air sampling system for the detection of airborne microorganisms The full AIR IDEAL® 3P® Traceability package comprises, along with the air sampler unit, remote control with embedded software and builtin 2Dbarcode scanner




Used Biomerieux Air Ideal 3p Traceability Air Sampling Monitor W Power Supply Lab General Un Venta Del La Dotmed Listado




Echantillonneur D Air Biomerieux Airideal 3p Gemini Bv
AeroBioCollector or Air sampler Air IDEAL 3P™ Traceability, instrument used to collect and count viable bacterial and fungal particles in a known and precise volume of air CFU Number of Colony Forming Units read on the agar plate The number of CFU corresponds to the number of clusters that have grown on the agarEasytouse, the Air IDEAL® 3P™ Traceability allows not only thorough air monitoring, but also a simple and efficient air circuit decontamination process Suitable for monitoring in all aseptic manufacturing areas ISO validated 21 CFR part 11 compliant Easy decontaminationAIR IDEAL 51 Windsor Avenue Mineola, New York Fax 147 West 35 th Street Suite 605 New York, NY




Used Biomerieux Air Ideal 3p Traceability Air Sampling Monitor W Power Supply Lab General Un Venta Del La Dotmed Listado



Ai3ptra1 Digital Device User Manual Ra C F Lcb
Find many great new & used options and get the best deals for Air Ideal 3p 90mm Plate Viable Air Sampler at the best online prices at eBay!Air IDEAL (90mm) air IDEAL® 3P is for the detection of viable organisms through active air sampling It uses standard prepared media, such as contact plates or 100mm platesReproducible air flow rate, calibrated by a scientifically sound metrological method Sequential sampling, for "in process" monitoring Light weight, with only 12 kg Specifications air IDEAL 3P ref Equipped with 90 mm diameter sampling grids air IDEAL 3P ref Equipped with 65/70 mm diameter sampling grids Accessories




Airideal 3p Data Nature




Sampl Air Biomerieux
AIR IDEAL 3P is for the detection of viable organisms through active air sampling It uses standard prepared media, such as contact plates or 100mm plates USES AIR IDEAL is used for Environmental monitoring;The alveolar air equation, therefore, can be used in the definition of factor A in the Coburn formula Simulation of the effect of altitude can be accomplished with the following empirical relationship r» ( P = 760 e 7924 where P = atmospheric pressure (torr) a = altitude above sea level in metersIdealAir™ is a supplier of heat pumps, air conditioners, humidifiers, dehumidifiers, ducting and HVAC accessories head quartered in the Pacific Northwest We design, manufacture, source and provide products that serve the Commercial, Residential and DoItYourself HVAC markets We stand behind what we sell for years of service and stock the




Echantillonneur D Air Biomerieux Airideal 3p Gemini Bv




Added By Pixcellstudios Instagram Post Contra Portada Tritico Desplegable Corporativo Ganbaro Equipos Vidas Vitek2 Bactalert Api Tempo Air Ideal 3p Sifin Portada Triptico Desplegable Desplegables Disenografico Disenografico Laboratorio
Free shipping for many products!AIR IDEAL® 3P® Máy lấy mẫu vi sinh trong không khí của BioMériux (Pháp) với hiệu quả thu nhận mẫu trong không khí cao nhờ dòng khí được tối ưu hóa và đáp ứng được các yêu cầu về dược phẩm, các tiêu chuẩn nghiêm ngặt nhất như CE, UL, CSA và ISO/DIS Mẫu vi sinh được thu nhận sẽ cố định trên đĩa môiComponents and accessories for the Air Ideal® air sampling monitorAir samplers are used to measure the air quality by determining the level of contaminates in a given volume of air Microbial air samplers with single and dual head configurations are available for continuous or sequential sampling that lasts for several hours These air sampling devices come in a wide variety that




Cruise The Best In Class Home Air Conditioners Residential Air Conditioning




Air Lift Performance 3s Brabant Custom Airride Parts
Biomerieux Air Ideal 3P 149 Visitors viewed Cambridge Scientific Products ads in the last 30 Days Send Request Ask for price Send to a Friend Equipment Location USA View Description> Hide Description Description of Biomerieux Air Ideal 3P Biomerieux Air Ideal 3P Item#AirIDEAL® 3P™ Traceability solution User manual for RUID remote control 4501 60 B – en – 11/01— P/N 4501 2232 SICAP Electronique ZA de la Lande CoudevillesurMer France Distributed by bioMérieux SA Marcy l'Étoile / France RCS Lyon 673 6 399 Tel 33 (0)4 78 87 00 Fax 33 (0)4 78 87 90BIOMERIEUX AIR IDEAL 3P Calibration TOTAL Calibration Solutions




Irradiated 3p Range Biomerieux Asean Countries




Labguard Biomerieux Asean Countries
Nov 15, · Used The Biomerieux Air IDEAL 3P air sampler used to detect the presence of viable microorganisms in the environment to be tested by precise sampling of a given volume of air Air is taken up with a turbine through a grid surface The acceleration of airflow results in the impaction of airborne microorganisms on the agarSep 30, 18 · The 2 1/2 hour block let you squeeze 5 wards into a building and led to jokes that tithing had been reduced to 75% (not really) This worked for us, but it wasn't ideal The lesson in priesthood was often reduced to 5 minutes due to opening exercises and long announcementsAIR IDEAL® 3P® is for the detection of viable organisms through active air sampling It uses standard prepared media, such as contact plates or 100mm plates




Airideal 3p Brochure




Microbial Air Sampler
Air IDEAL® 3P bioMérieux ընկերության օդի նմուշառման air IDEAL® 3P համակարգը նոր ստանդարտ է օդային միջավայրի մանրէաբանական ստուգման Նմուշառման կենսաբանական էֆեկտիվությունը վալիդացված է անկախReproducible air flow rate, calibrated by a scientifically sound metrological method Sequential sampling, for "in process" monitoring Light weight, with only 12 kg Specifications air IDEAL 3P ref Equipped with 90 mm diameter sampling grids air IDEAL 3P ref Equipped with 65/70 mm diameter sampling grids AccessoriesA trusted NY Metro area and Western Long Island HVAC contractor for commercial and highend residential HVAC, design, repair and preventive maintenance, Air Ideal leverages more than 90 years of engineering and design experience to deliver its awardwinning service



Katkars Clinical Industrial Products




Sistema Probootbora Vozduha Dlya Obnaruzheniya Vozdushnyh Mikroorganizmov Biomerieux Air Ideal 3p Traceability Kupit V Minske Theseus Lab
Air Flow calibration, Biomerieux AirIdeal 3P, Get your Biomerieux AirIdeal 3P calibrated by the experts at CIH Equipment Company call , ISO Accredited labThe bioMérieux AIR IDEAL® 3P® microbial air sampler has been third part validated by the HPA for biological e˜ ciency following the ISO standard The AIR IDEAL® 3P® was shown to be able to collect aerosols of Staphylococcus epidermidis with a high e˜ ciency of 921%Used Biological Air Samplers We are constantly receiving a range of used biological air samplers from a number of respected OEMs These OEMs include Biotest Hycon, Millipore, Veltek Associates Inc and many others Our inventory of used biological air samplers sources a number of industries with the ideal equipment solutions they are looking for




Air Ideal 3p Powerful And Simple Air Testing Biomerieux Industrial Microbiology




Air Lift Performance 3h 3p Manifold 1 4 Classy House Productions
The air sampler of the brand Biomerieux type Airideal 3P is designed for air quality control and environmental monitoring for, among others, clinical laboratories This air sampler includes userfriendly software with storage for sampling parameters In addition, this air sampler is equipped with an audible and visible alarm at the end of theFácil de usar, o sistema AIR IDEAL® 3P® Traceability não só permite um monitoramento exaustivo do ar, mas também um circuito simples e eficiente para o processo de descontaminação Adequado para o monitoramento em todas as áreas assépticas de fabricação Validada para ISO Cumpre com CFR 21 parte 11 Fácil descontaminaçãoIdeal law, and Charbonier had deteriiined the F exponent from an actual borab test, by setting on the ,p, t curve the maximum pressure p and pressure pi at the point of inflexion;P (48) Pi The more uniform will be the burning of the powder, the higher will be the point of inflexion, the smaller the numerator, and the




Air Ideal 3ptm Traceability Biomerieux




Air Ideal 3p Biomerieux Industry Usa
The air IDEAL 3P engine, electronic components and seals have been totally redesigned to meet the strict constraints of isolator use ppm 300 The ability of air IDEAL 3P to be used in isolators has been evaluated by the SKAN's Center of Competence for Isolator technologyMáy lấy mẫu không khí bioMérieux AIR IDEAL 3P được tin tưởng và sử dụng rộng rãi trong ngành sản xuất dược phẩm, tuân thủ theo tiêu chuẩn ISO MáyAIR IDEAL® 3P is for the detection of viable organisms through active air sampling It uses standard prepared media, such as contact plates or 100mm plates




Used Biomerieux Air Ideal 3p Traceability Air Sampling Monitor W Power Supply Lab General Un Venta Del La Dotmed Listado




Un Acteur Majeur Du Diagnostic In Vitro Ppt Telecharger




Spin Air Samplers Grant Users A Compact And Portable Solution Iul




Air Lift Performance 1 4ƒ Threaded Fnpt Port Alp 3h 3p Manifold




Air Ideal 3p Powerful And Simple Air Testing Biomerieux Industrial Microbiology




Biomerieux A3p Industrie Pharmaceutique Biotechnologie




Buy Slim40i 40l Slim Evaporative Air Cooler And Antibacterial Air Purifier For Areas Up To 45 Sqm From Aircon Direct




Luftkeimsammlung




Air Ideal 3p Powerful And Simple Air Testing Biomerieux Industrial Microbiology




Echantillonneur D Air Biomerieux Airideal 3p Gemini Bv




Biomerieux Australia Food Processing Technology




Used Biomerieux Air Ideal 3p Traceability Air Sampling Monitor W Power Supply Lab General Un Venta Del La Dotmed Listado




Echantillonneur D Air Biomerieux Airideal 3p Gemini Bv




Preleveur D Air Airtest Biocollecteur




Produktovy Katalog Klinika Pdf Free Download




Air Ideal 3p Powerful And Simple Air Testing Biomerieux Industrial Microbiology




Air Ideal 3p Traceability For Sale In Fort Lauderdale Fl Offerup




Airideal 3p Brochure

Biomerieux A3p Industrie Pharmaceutique Biotechnologie




Biomerieux Microbiological Air Sampler Air Ideal 3p For Clean Room Airideal Eur 763 16 Picclick Fr




3 Setup And Start Of Air Ideal And Particle Counter 2 Youtube



Biomerieux Air Ideal 3p User Manual




Andrea Giovannini Urgences




Lcb Ai3ptra1 Digital Device User Manual R F




Suppliers Of Intruments For Air Sampling And Air Monitoring




Automated Systems Yunycom Yunycom




Em From Variable Operator Numeration To The 3p Station




Biomerieux Air Ideal 3p Traceability Air Sampling Monitor Cracked Casing For Sale Online Ebay




Air Ideal Ai One Stage Impactor Used During The Study Download Scientific Diagram




Biomerieux Microbiological Air Sampler Air Ideal 3p For Clean Room Airideal Eur 763 16 Picclick Fr




Used Biomerieux Air Ideal 3p Traceability Air Sampling Monitor W Power Supply Lab General Un Venta Del La Dotmed Listado




Ai3ptra1 Digital Device User Manual Ra C F Lcb




Xjos53 Ui3e7km




Laboratorios Bioquality Servicios




Biomerieux Air Ideal 3p Luftkeimsammler Mikroskopobjektiv G




Biomerieux Microbiological Air Sampler Air Ideal 3p For Clean Room Airideal



Katkars Clinical Industrial Products



Ai3ptra1 Digital Device User Manual Ra C F Lcb



Sv Medico จำหน ายอ ปกรณ ว ทยาศาสตร อ ปกรณ การแพทย Air Ideal 3p




Buy Agni Solar Inflatable Light 3p Solar Led Light Water Proof Ag Lap White Online Croma




Laboratorios Bioquality Photos Facebook




Biomerieux Microbiological Air Sampler Air Ideal 3p For Clean Room Airideal Eur 763 16 Picclick Fr




Air Ideal Biomerieux



Ai3ptra1 Digital Device User Manual Ra C F Lcb




Air Ideal Biomerieux



Osa Anisoplanatism In Airborne Laser Communication




Em From Variable Operator Numeration To The 3p Station



Ai3ptra1 Digital Device User Manual Ra C F Lcb




Biomerieux Microbiological Air Sampler Air Ideal 3p For Clean Room Airideal Eur 763 16 Picclick Fr




Biomerieux Air Ideal 3p Traceability Air Sampling Monitor Cracked Casing For Sale Online Ebay




Echantillonneur D Air Biomerieux Airideal 3p Gemini Bv




Artemis Airgun Marque De Snow Peak Airgun Spa




Un Acteur Majeur Du Diagnostic In Vitro Ppt Telecharger



Ai3ptra1 Digital Device User Manual Ra C F Lcb




V Yakutske Protestirovali Recirkulyator Dlya Obezzarazhivaniya Vozduha V Passazhirskom Avtobuse Yakutiamedia




Biomerieux Air Ideal 3p Environmental Air Monitor Airborne Aerobiocollector Ebay




Biomerieux Air Ideal 3p User Manual Pdf Download Manualslib




Simed Photos Facebook




Brands Farminpex N V Medical Equipment Curacao




Biomerieux Air Ideal 3p Traceability Air Sampling Monitor Cracked Casing For Sale Online Ebay




Biomerieux Microbiological Air Sampler Air Ideal 3p For Clean Room Airideal Eur 763 16 Picclick Fr



Katkars Clinical Industrial Products




Biomerieux Microbiological Air Sampler Air Ideal 3p For Clean Room Airideal Eur 763 16 Picclick Fr




Z630 3p Datasheet Manualzz




Sistema Probootbora Vozduha Dlya Obnaruzheniya Vozdushnyh Mikroorganizmov Biomerieux Air Ideal 3p Traceability Kupit V Minske Theseus Lab




Air Optix Aqua Multifocal 3p Buy Contact Lenses Online Lenshop




Biomerieux Air Ideal 3p User Manual Pdf Download Manualslib



0 件のコメント:
コメントを投稿